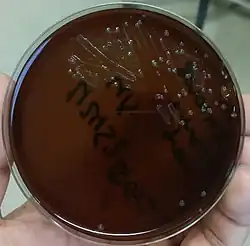

Neisseria gonorrhoeae
| Neisseria gonorrhoeae | |
|---|---|
| |
| Gram-stain of gonococcal urethritis. Note distribution in neutrophils and presence of both intracellular and extracellular bacteria. (CDC) | |
| Scientific classification | |
| Domain: | Bacteria |
| Kingdom: | Pseudomonadati |
| Phylum: | Pseudomonadota |
| Class: | Betaproteobacteria |
| Order: | Neisseriales |
| Family: | Neisseriaceae |
| Genus: | Neisseria |
| Species: | N. gonorrhoeae
|
| Binomial name | |
| Neisseria gonorrhoeae | |
| Synonyms | |
Neisseria gonorrhoeae, also known as gonococcus (singular) or gonococci (plural), is a species of Gram-negative diplococci bacteria first isolated by Albert Neisser in 1879.[3] An obligate human pathogen, it primarily colonizes the mucosal lining of the urogenital tract; however, it is also capable of adhering to the mucosa of the nose,[4] pharynx, rectum, and conjunctiva.[5] It causes the sexually transmitted genitourinary infection gonorrhea[6] as well as other forms of gonococcal disease including disseminated gonococcemia, septic arthritis, and gonococcal ophthalmia neonatorum.
N. gonorrhoeae is oxidase positive and a microaerophile that is capable of surviving phagocytosis and growing inside neutrophils.[6] Culturing it requires carbon dioxide supplementation and enriched agar (chocolate agar) with various antibiotics (Thayer–Martin). It exhibits antigenic variation through genetic recombination of its pili and surface proteins that interact with the immune system.[3]
Sexual transmission is through vaginal, anal, or oral sex.[7] Sexual transmission may be prevented through the use of barrier protection.[8] Perinatal transmission may occur during childbirth, though it is preventable through antibiotic treatment of the mother before birth and application of antibiotic eye gel on the eyes of the newborn.[8] Gonococcal infections do not result in protective immunity; therefore, individuals may be infected multiple times. Reinfection is possible due to N. gonorrhoeae's ability to evade the immune system by varying its surface proteins.[9]
Asymptomatic infection is common in both males and females.[8][10] Untreated infection may spread to the rest of the body (disseminated gonorrhea infection), especially the joints (septic arthritis). Untreated infection in women may cause pelvic inflammatory disease and possible infertility due to the resulting scarring.[11] Gonorrhoea is diagnosed through cultures, Gram staining, or nucleic acid tests (i.e. polymerase chain reaction) of urine samples, urethral swabs, or cervical swabs.[12][13] Chlamydia co-testing and testing for other STIs is recommended due to high rates of co-infection.[14]
Antibiotic resistance in N. gonorrhoeae is a growing public health concern, especially given its propensity to develop resistance easily.[15] This ability of N. gonorrhoeae to rapidly adapt to novel antimicrobial treatments has been seen several times since the 1930s, making numerous treatment plans obsolete. Some strains have exhibited resistance to the current ceftriaxone treatments.[16]
Microbiology

Neisseria species are fastidious, Gram-negative cocci (though some species are rod-shaped and occur in pairs or short chains) that require nutrient supplementation to grow in laboratory cultures.[18] They are facultative intracellular pathogens, meaning they can persist and colonize within host cells but can also multiply outside the host cellular environment.[19][20][21] They typically appear in pairs (diplococci), resembling the shape of coffee beans.[21] Members of this genus do not form endospores and are nonmotile, except for pathogenic species, which are capable of moving using twitching motility;[22] most are also obligate aerobes.[23][24] Of the 17 species that colonize humans, only two are pathogenic: N. gonorrhoeae, which causes gonorrhea, and N. meningitidis, a leading cause of bacterial meningitis.[25][26]
Culture and identification

N. gonorrhoeae can be isolated on Thayer–Martin agar (or VPN) agar in an atmosphere enriched with 3-7% carbon dioxide.[12] Thayer–Martin agar is a chocolate agar plate (heated blood agar) containing nutrients and antimicrobials (vancomycin, colistin, nystatin, and trimethoprim). This agar preparation facilitates the growth of Neisseria species while inhibiting the growth of contaminating bacteria and fungi. Martin Lewis and New York City agar are other types of selective chocolate agar commonly used for Neisseria growth.[12] N. gonorrhoeae is oxidase positive (possessing cytochrome c oxidase) and catalase positive (able to convert hydrogen peroxide to oxygen).[12] When incubated with the carbohydrates lactose, maltose, sucrose, and glucose, N. gonorrhoeae will oxidize only the glucose.[12]
Metabolism
Carbon
Unlike other Neisseria species that can also metabolize maltose, N. gonorrhoeae is capable of using only glucose, pyruvate, and lactate as central carbon sources, and glucose is catabolized via both the Entner-Doudoroff (ED) and pentose phosphate (PP) pathways, and the ED pathway is the primary oxidative method.[19][27] Use of these pathways is necessary as N. gonorrhoeae is incapable of glucose catabolism via the Embden-Meyerhof-Parnas (EMP) pathway due its lack of the phosphofructokinase (PFK) gene; however, the fructose 1,6-bisphosphatase enzyme is present to allow for gluconeogenesis to occur.[19]
Glucose is first metabolized through the ED pathway to produce pyruvate and glyceraldehyde 3-phosphate, the latter of which can then further metabolized by enzymes of the EMP pathway to yield another molecule of pyruvate.[28] The resultant pyruvate molecules are then converted into acetyl-CoA, which can then be incorporated as a substrate for the citric acid cycle (CAC) to yield high-energy electron carriers that will be used by the electron transport chain (ETC) for ATP production; however, the CAC is largely used for generating biosynthetic precursors rather than for catabolic purposes.[19][29] This is due in part to inhibited expression of several CAC enzymes in the presence of glucose, pyruvate, or lactate. These enzymes, namely citrate synthase, aconitase, and isocitrate dehydrogenase, are needed for the incorporation of acetate. Instead, a partial CAC has been observed, where α-ketoglutarate is formed by glutamate dehydrogenase or transamination of oxaloacetate and glutamate by aspartate aminotransferase (yielding aspartate and α-ketoglutarate).[27][29] The CAC then continues from there to yield oxaloacetate, which is an important precursor molecule for several biosynthetic pathways.[29] Another differentiating aspect of the gonococcal CAC is the lack of malate dehydrogenase, which is instead replaced by a membrane-bound malate:quinone-oxidoreductase that operates independently of NAD+ by directly transferring electrons to ubiquinone.[19]
Conversely, acetyl-CoA that does not enter the CAC but enters the phosphotransacetylase-acetate kinase (PTA-AckA) pathway, where it can be converted into acetate by phosphorylation (to form acetyl phosphate and release coenzyme A) and dephosphorylation to form ATP.[30] While this acetate can enter the CAC for further oxidation, this does not occur so long as other carbon sources such as glucose or lactate are present, in which case it is excreted from the cell or incorporated for lipid synthesis.[28][31] N. gonorrhoeae lack the glyoxylate shunt, preventing them from using acetate to form CAC intermediates to replenish the cycle.[28][27]
A significant portion of the glyceraldehyde 3-phosphate formed in gonococci is recycled via the gluconeogenic pathway to reform glucose 6-phosphate, as well as the intermediate fructose 6-phosphate. Both of these can then be used for pentose synthesis in the PP pathway via the oxidative and non-oxidative pathways, respectively, for subsequent nucleotide formation as well as energy production.[27]
N. gonorrhoeae, like other pathogenic members of the genus Neisseria, are capnophiles, meaning they require higher-than-normal concentrations of carbon dioxide (CO2) to grow, either in the form of CO2 or bicarbonate (HCO3−) depending on the bacterial strain. This requirement must be met exogenously during the lag and stationary growth phases, though it appears to be met through high metabolic CO2 productions in the exponential phase. Assimilation of this CO2 in Neisseria species is done by carbonic anhydrase and phosphoenolpyruvate enzymes in the periplasmic space and the cytoplasm, respectively.[27]
Lactate catabolism is also of particular importance for gonococci, both for pathogenicity and for growth.[19] External lactate is transported in to the cell via lactate permease (LctP).[19] The N. gonorrhoeae genome encodes for three lactate dehydrogenase (LDH) enzymes for that allow for metabolism of both L-lactate and D-lactate: a cytoplasmic NAD+-dependent D-lactate dehydrogenase (LdhA), which is responsible for and two membrane-bound LDHs, one specific to L-lactate (LldD) and the other specific to D-lactate (LdhD).[19][32] The membrane-bound LDHs have been determined to be flavoprotein-containing respiratory enzymes that directly oxidize lactate to reduce ubiquinone. While these enzymes do not directly pump protons (H+ ions) into the periplasmic space, it is proposed that the reduction of ubiquinone by these enzymes is capable of feeding into the larger ETC.[32]
Electron transport chain and oxidative phosphorylation
As an obligate human pathogen and a facultative anaerobic capnophile, Neisseria gonorrhoeae typically colonizes mucosal surfaces in microaerobic environments, such as those in the genitourinary tract.[19] Growth in areas where oxygen concentrations are limited requires a terminal oxidase with a high affinity for oxygen; in gonococci, oxygen reduction is performed by a ccb3 -type cytochrome oxidase. In addition to aerobic respiration, gonococci can also perform anaerobic respiration via the reduction of nitrite (NO2) to nitric oxide (NO) as well as reduction of NO to nitrous oxide (N2O).[19][33]
Several enzymes contribute electrons to the intramembranous ubiquinone pool, the first step in the ETC. These include the membrane-bound LDHs (LldD and LdhD), NADH:ubiquinone oxidoreductase (aka NADH dehydrogenase; Nuo complex I), Na+-translocating NADH dehydrogenase (Nqr), succinate dehydrogenase (SDH), and the membrane-bound NAD+-independent malate:quinone-oxidoreductase (MqR).[19]
Following the initial transfer of electrons to ubiquinone, proposed schematics for the organization of the gonococcal ETC suggest the electrons can be further passed down the chain by reduction of the cytochrome bc1 complex or can be directly transferred to NO as a terminal electron acceptor by NO reductase (NorB).[19][34] In the case of the former, electrons can then be passed from the bc1 complex along two alternative pathways via the reduction of either cytochrome c4 or c5. Both of these cytochromes transfer electrons to the terminal cytochrome ccb3 oxidase for the reduction of O2 to form H2O under aerobic conditions.[19][33]
Gonococci also reduce NO2 via an inducible outer membrane-attached copper-containing nitrite reductase (AniA, a member of the NirK protein family) under anaerobic conditions, though this process has also been noted in microaerobic conditions as a means of supplementing growth.[34] This leads to the formation of NO that is subsequently reduced to N2O in a partial denitrification pathway.[19][33][34] The ccb3 oxidase of N. gonorrhoeae, dissimilarly to other members of the Neisseria genus, is a tri-heme protein that can transfer electrons not only to O2 (conserved across Neisseria species) but also to AniA for NO2 reduction. This is in addition to the typical process of receiving electrons transferred from cytochrome c5.[34][35]
The general purpose of the ETC is the formation of the electrochemical gradient of hydrogen ions (H+ or protons), resulting from concentration differences across the plasma membrane, needed to power ATP production in a process known as oxidative phosphorylation.[36] In gonococci, movement of protons into the periplasmic space is accomplished by the Nuo complex I, the cytochrome bc1 complex, and cytochrome ccb3.[19][34][37] Subsequently, ATP synthesis is performed by the F1F0 ATP synthase, a two-part protein complex present in gonococci as well as numerous other species across phylogenetic domains.[38] This complex couples proton translocation back into the cytoplasm along its gradient with mechanical rotation to generate ATP.[39]
Iron
The general purpose of the ETC is the formation of the electrochemical gradient of hydrogen ions (H+ or protons), resulting from concentration differences across the plasma membrane, needed to power ATP production in a process known as oxidative phosphorylation.[36] In gonococci, movement of protons into the periplasmic space is accomplished by the Nuo complex I, the cytochrome bc1 complex, and cytochrome ccb3.[19][34][37] Subsequently, ATP synthesis is performed by the F1F0 ATP synthase, a two-part protein complex present in gonococci as well as numerous other species across phylogenetic domains.[38] This complex couples proton translocation back into the cytoplasm along its gradient with mechanical rotation to generate ATP.[39]
To acquire the necessary iron, gonococci produce TonB-dependent transporters (TDTs) on the surface of their outer membrane that can directly extract iron, along with other metals, from their respective carrier proteins. Some of these include transferrin binding proteins A (TbpA) and B (TbpB), lactoferrin-binding proteins A (LbpA) and B (LbpB), and hemoglobin/hemoglobin-haptoglobin binding proteins HpuB and HpuA.[19][40] In addition to these proteins, gonococci are also capable of using siderophores, or compounds that are capable of chelating iron in the environment, that are produced by other bacteria; however, gonococcal cells are incapable of synthesizing siderophores themselves. These xenosiderophores are taken up by the TDT FetA through the outer membrane and then brought into the cell by the fetBCDEF transporter system.[19][40]
Along with the sequestration defence that can be further upregulated by host inflammation, humans also produce siderocalins that can chelate siderophores as a further method of inhibiting pathogenic bacterial growth. These are sometimes ineffective against N. gonorrhoeae, which can colonize intracellularly, particularly in phagocytic cells such as macrophages and neutrophils. Increases in host intracellular iron also downregulate some of the intracellular pathogen-killing mechanisms; coincidentally, pathogenic Neisseria can alter several host cell mechanisms that ultimately allow the pathogen to take most of the available iron from the host immune cell.[40]
Surface molecules
On its surface, N. gonorrhoeae bears hair-like pili, surface proteins with various functions, and sugars called lipooligosaccharide. The pili mediate adherence, movement, and DNA exchange. The opacity-associated (Opa) proteins interact with the immune system, as do the porins. Lipooligosaccharide is an endotoxin that provokes an immune response. All of these are antigenic and exhibit antigenic variation. The pili, Opa proteins, porins, and even the lipooligosaccharide have mechanisms to inhibit the immune response, making asymptomatic infection possible.[41]
Opa proteins
Phase-variable opacity-associated (Opa) adhesin proteins are used by N. gonorrhoeae as part of evading the immune response in a host cell. At least 12 Opa proteins are known, and the many variations of surface proteins make recognizing N. gonorrhoeae and mounting a defense by immune cells more difficult.[42] Opa proteins are in the outer membrane and facilitate a response when the bacteria interacts with a variety of host cells. These proteins bind to various epithelial cells, and allow N. gonorrhoeae to increase the length of infection as well as increase the amount of invasion into other host cells.[43]
Type IV pili

Dynamic polymeric protein filaments called type IV pili allow N. gonorrhoeae to do many bacterial processes, including adhesion to surfaces, transformation competence, twitching motility, and immune response evasions.[19] To enter the host the bacteria uses the pili to adhere to and penetrate mucosal surfaces. The pili are a pivotal virulence factor for N. gonorrhoeae; without them, the bacterium is unable to promote colonization.[44] For motility, individual bacteria use their pili in a manner that resembles a grappling hook: first, they are extended from the cell surface and attach to a substrate. Subsequent pilus retraction drags the cell forward. The resulting movement is referred to as twitching motility. N. gonorrhoeae can pull 100,000 times its own weight,[45] and the pili used to do so are amongst the strongest biological motors known to date, exerting one nanonewton.[45] The PilF and PilT ATPase proteins are responsible for powering the extension and retraction of the type IV pilus, respectively. The adhesive functions of the gonococcal pilus play a role in microcolony aggregation and biofilm formation. These pili are also used to avoid immune responses from the cell they are invading by having their type IV pili antigenically vary. The main pilus filament is replaced by variable DNA sequences very frequently.[19] By doing this process rapidly, they can create a diversity of pili on their surface and evade the host cell's immune response.[44]
Lipooligosaccharide
Lipooligosaccharide is a low-weight version of lipopolysaccharide present on the surfaces of most other Gram-negative bacteria. It is a sugar (saccharide) side chain attached to lipid A (thus "lipo-") in the outer membrane coating the cell wall of the bacteria. The root "oligo" refers to the fact that it is a few sugars shorter than the typical lipopolysaccharide.[6] As an endotoxin, it provokes inflammation. The shedding of lipooligosaccharide by the bacteria is sometimes responsible for issues associated with pelvic inflammatory disease.[6] Although it functions primarily as an endotoxin, lipooligosaccharide may disguise itself with host sialic acid and block initiation of the complement cascade.[6]
Antigenic variation
N. gonorrhoeae evades the immune system through a process called antigenic variation.[46] This process allows N. gonorrhoeae to recombine its genes and alter the antigenic determinants that adorn its surface,[6] such as the Type IV pili.[47] Simply stated, the chemical composition of molecules are changed due to changes at the genetic level.[9] N. gonorrhoeae is able to vary the composition of its pili and lipooligosaccharide. Of these, the pili exhibit the most antigenic variation due to chromosomal rearrangement.[11][6] The pilS gene is an example of this ability to rearrange, as its combination with the pilE gene is estimated to produce over 100 variants of the PilE protein.[9] These changes allow for adjustment to local environmental differences at the site of infection, evasion of recognition by targeted antibodies, and inhibit the formation of an effective vaccine.[9]
In addition to gene rearrangement, it is also naturally competent, meaning it can acquire extracellular DNA from the environment via its type IV pilus, specifically proteins PilQ and PilT.[48] These processes allow N. gonorrhoeae to acquire and spread new genes, disguise itself with different surface proteins, and prevent the development of immunological memory – an ability which has contributed to antibiotic resistance and impeded vaccine development.[49]
Phase variation
Phase variation is similar to antigenic variation, but instead of changes at the genetic level altering the composition of molecules, these genetic changes result in the activation or deactivation of a gene.[9] Phase variation most often arises from a frameshift in the expressed gene.[9] The Opa proteins of N. gonorrhoeae rely strictly on phase variation.[9] Every time the bacteria replicate, they may switch multiple Opa proteins on or off through slipped-strand mispairing. That is, the bacteria introduce frameshift mutations that bring genes in or out of frame. The result is that different Opa genes are translated every time.[6] Pili are varied by antigenic variation, but also phase variation.[9] Frameshifts occur in both the pilE and pilC genes, effectively turning off the expression of pili in situations when they are not needed, such as during intracellular colonization as opposed to extracellular mucosal cell surface adhesion.[9]
Survival of gonococci
After gonococci invade and transcytose the host epithelial cells, they land in the submucosa, where neutrophils promptly consume them.[6] The pili and Opa proteins on the surface may interfere with phagocytosis,[11] but most gonococci end up in neutrophils. The exudates from infected individuals contain many neutrophils with ingested gonococci. Neutrophils release an oxidative burst of reactive oxygen species in their phagosomes to kill the gonococci.[50] However, a significant fraction of the gonococci can resist killing through the action of their catalase,[6] which breaks down reactive oxygen species and can reproduce within the neutrophil phagosomes.[51]
The bacterial RecA protein, which mediates repair of DNA damage, plays a crucial role in gonococcal survival.[52] N. gonorrhoeae may replace DNA damaged in neutrophil phagosomes with DNA from neighboring gonococci.[53] The process in which recipient gonococci integrate DNA from neighboring gonococci into their genome is called transformation.[54]
Genome
The genomes of several strains of N. gonorrhoeae have been sequenced. Most of them are about 2.1 Mb in size and encode 2,100 to 2,600 proteins (although most seem to be in the lower range).[55] For instance, strain NCCP11945 consists of one circular chromosome (2,232,025 bp) encoding 2,662 predicted open reading frames (ORFs) and one plasmid (4,153 bp) encoding 12 predicted ORFs. The estimated coding density over the entire genome is 87%, and the average G+C content is 52.4%, values that are similar to those of strain FA1090. The NCCP11945 genome encodes 54 tRNAs and four copies of 16S-23S-5S rRNA operons.[56]
Horizontal gene transfer
Horizontal gene transfer, also termed lateral gene transfer, is the sharing of genetic information amongst living organisms.[57] This transmission of information is a driving force of antibiotic resistance in N. gonorrhoeae.[58][59] Studies have identified that N. gonorrhoeae has obtained methods of antimicrobial resistance by way of horizontal gene transfer from other Neisseria species including N. lactamica, N. macacae, and N. mucosa. [60]
Transformation in N. gonorrhoeae is performed by the type IV pilus, where the DNA is bound and brought into the cell, followed by processing and homologous recombination.[61]
Found in some genomes of Neisseria gonorrhoeae, the gonococcal genetic island (GGI), a genomic island (GI) specific to gonococci, has been identified as a mobile genetic element that is horizontally acquired.[62][63] GGI is involved with antimicrobial resistance, transmission of genetic information, and iron acquisition.[62] The genes within the gonococcal genetic island encode for the infamous type IV secretion system (T4SS), which is responsible for DNA secretion and is essential for biofilm formation.[62][64]
In 2011, researchers at Northwestern University found evidence of a human DNA fragment in a N. gonorrhoeae genome, the first example of horizontal gene transfer from humans to a bacterial pathogen.[65][66]
Disease
Symptoms
Symptoms of infection with N. gonorrhoeae differ depending on the site of infection and many infections are asymptomatic independent of sex.[67][41][7] Depending on the route of transmission, N. gonorrhoeae may cause infection of the throat (pharyngitis) or infection of the anus/rectum (proctitis).[68][11]
Disseminated gonococcal infections can occur when N. gonorrhoeae enters the bloodstream, often spreading to the joints and causing a rash (dermatitis-arthritis syndrome).[68] Dermatitis-arthritis syndrome results in joint pain (arthritis), tendon inflammation (tenosynovitis), and painless non-pruritic (non-itchy) dermatitis.[11] Disseminated infection and pelvic inflammatory disease in women tend to begin after menses due to reflux during menses, facilitating spread.[68] In rare cases, disseminated infection may cause infection of the meninges of the brain and spinal cord (meningitis) or infection of the heart valves (endocarditis).[68][69]
Male
In symptomatic men, the primary symptom of genitourinary infection is urethritis – burning with urination (dysuria), increased urge to urinate, and a pus-like (purulent) discharge from the penis. The discharge may be foul-smelling.[68] If untreated, scarring of the urethra may result in difficulty urinating. Infection may spread from the urethra in the penis to nearby structures, including the testicles (epididymitis/orchitis), or to the prostate (prostatitis).[68][11][70]
Female
.jpg)
In symptomatic women, the primary symptoms of genitourinary infection are increased vaginal discharge, burning with urination (dysuria), increased urge to urinate, pain with intercourse, or menstrual abnormalities. Pelvic inflammatory disease results if N. gonorrhoeae ascends into the pelvic peritoneum (via the cervix, endometrium, and fallopian tubes). The resulting inflammation and scarring of the fallopian tubes can lead to infertility and an increased risk of ectopic pregnancy.[68] Pelvic inflammatory disease develops in 10 to 20% of the females infected with N. gonorrhoeae.[68]
Neonates (perinatal infection)
In perinatal infection, the primary manifestation is infection of the eye (neonatal conjunctivitis or ophthalmia neonatorum) when the newborn is exposed to N. gonorrhoeae in the birth canal. The eye infection can lead to corneal scarring or perforation, ultimately resulting in blindness. If the newborn is exposed during birth, conjunctivitis occurs within 2–5 days after birth and is severe.[68][69] Gonococcal ophthalmia neonatorum, once common in newborns, is prevented by the application of erythromycin (antibiotic) gel to the eyes of babies at birth as a public health measure. Silver nitrate is no longer used in the United States.[69][68]
Transmission
N. gonorrhoeae is most often transmitted through vaginal, oral, or anal sex; nonsexual transmission is unlikely in adult infection.[7] It can also be transmitted to a newborn during passage through the birth canal if the mother has an untreated genitourinary infection. Given the high rate of asymptomatic infection, it is recommended that pregnant women be tested for gonococcal infection before birth.[7] Communal baths, shared towels or fabrics, rectal thermometers, and improper hand hygiene by caregivers have been identified as potential means of transmission in pediatric settings.[71]
Traditionally, the bacterium was thought to move attached to spermatozoa, but this hypothesis did not explain female-to-male transmission of the disease. A recent study suggests that rather than "surf" on wiggling sperm, N. gonorrhoeae bacteria use pili to anchor onto proteins in the sperm and move through coital fluid.[72]
Infection
Successful transmission is followed by adherence to the epithelial cells found at the infected mucosal site by the bacterium's type IV pili. The pili's ability to attach and subsequently retract pulls N. gonorrhoeae towards the epithelial membrane at the surface of the mucosal cell.[15] Post attachment, N. gonorrhoeae replicates its genome and divides to form microcolonies.[15] Gonococcal infection is sometimes aided by the membrane cofactor protein, CD46, as it has been known to act as a receptor for gonococcal pilus.[41] Additionally, interaction with pili has been shown to cause cytoskeletal rearrangement of the host cell, further demonstrating that gonococcal pili engagement disrupts the response of the host cell and increases the likelihood of successful infection.[41] During growth and colonization, N. gonorrhoeae stimulates the release of pro-inflammatory cytokines and chemokines from host immune cells that result in the recruitment of neutrophils to the area.[9] These phagocytic cells typically take in foreign pathogens and destroy them; however, N. gonorrhoeae's ability to manipulate the host cell response allows the pathogen to survive within these immune cells and evade elimination.[9]
Laboratory diagnosis
The primary detection methods for Neisseria gonorrhoeae are nucleic acid amplification tests, which are the most sensitive techniques available.[73][74] Other methods of detection include microscopy and culture.[73]
Prevention
Transmission is reduced by using latex barriers (e.g., condoms or dental dams) during sex and by limiting sexual partners.[8] Condoms and dental dams should be used during oral and anal sex as well. Spermicides, vaginal foams, and douches are not effective methods for transmission prevention.[6]
Vaccine
A vaccine against N. gonorrhoeae is becoming more necessary due to the growing incidence of cases, increasing antimicrobial resistance, and its impact on reproductive health.[75] There are problems that have hampered vaccine development including: the absence of immunity post-infection, exclusively human hosts, and antigenic and phase variation of potential vaccine targets.[76] Currently, there are several N. gonorrhoeae vaccines in development, including an outer membrane vesicle vaccine.[76] This includes the NGoXIM, the native OMV, and Bexsero/4CMenB vaccine candidates, which are all in the late clinical stages of development.[77] The creation of a vaccine for N. gonorrhoeae has several potential public health impacts. In one estimate, a vaccine for the heterosexual population given before sexual activity occurs showed that the prevalence of N. gonorrhoeae could be reduced by up to 90% after 20 years.[76]. In 2023, the FDA gave fast-track designation to a gonorrhoea vaccine candidate from GSK [78] . NHS England has also launched the world's first vaccination program against gonorrhea, using a vaccine against Neisseria meningitidis which was found to be partially effective against N. gonorrhoeae [79][80] .
Treatment
Currently, the CDC recommends a single dose of the injectable cephalosporin, ceftriaxone, as the first line of defense against gonococcal infections.[81] Individuals weighing less than 150 kg are typically prescribed a ceftriaxone concentration of 500 mg, while individuals who weigh over 150 kg are typically prescribed a dose of 1 g. Although ceftriaxone is not the only cephalosporin that has been effective at treating gonorrhoeae, it is the most advantageous.[75] In the event of a cephalosporin allergy, the CDC recommends a dual treatment of gentamicin and azithromycin. Each drug should be administered as a single dose, with the gentamicin entering intramuscularly at a concentration of 240 mg, along with 2 g of azithromycin taken orally.[75] If an individual is not allergic to cephalosporins but ceftriaxone is unavailable, an alternative treatment is a single dose of 800 mg cefixime consumed orally.[75] In all of these cases, combination therapy and co-treatment for chlamydia is recommended, as simultaneous infections are common.[82]
Antibiotic resistance
Antibiotic resistance in gonorrhea was first identified in the 1940s. Gonorrhea was treated with penicillin, but doses had to be progressively increased to remain effective. By the 1970s, penicillin-and tetracycline-resistant gonorrhea emerged in the Pacific Basin. These resistant strains then spread to Hawaii, California, the rest of the United States, Australia and Europe. Fluoroquinolones were the next line of defense, but soon resistance to this antibiotic emerged, as well. Since 2007, standard treatment has been third-generation cephalosporins, such as ceftriaxone, which are considered to be our "last line of defense".[83][84] Recently, a high-level ceftriaxone-resistant strain of gonorrhea called H041 was discovered in Japan. Lab tests found it to be resistant to high concentrations of ceftriaxone, as well as most of the other antibiotics tested. Within N. gonorrhoeae, genes exist that confer resistance to every single antibiotic used to cure gonorrhea, but thus far, they do not coexist within a single gonococcus. However, because of N. gonorrhoeae's high affinity for horizontal gene transfer, antibiotic-resistant gonorrhea is seen as an emerging public health threat.[84]
Before 2007, fluoroquinolones were a common treatment recommendation for gonorrhoeae. The CDC stopped suggesting these systemic bacterial agents once a resistant strain of N. gonorrhoeae emerged in the United States. The removal of fluoroquinolones as a potential treatment left cephalosporins as the only viable antimicrobial option for gonorrhea treatment. Wary of further gonococcal resistance, the CDC's recommendations shifted in 2010 to a dual therapy strategy—cephalosporin with either azithromycin or doxycycline. Despite these efforts, resistant N. gonorrhoeae had been reported in five continents by 2011, further limiting treatment options and recommendations. Antimicrobial resistance is not universal and N. gonorrhoeae strains in the United States continue to respond to a combination regimen of ceftriaxone and azithromycin.[85]
Serum resistance
As a Gram negative bacterium, N. gonorrhoeae requires defense mechanisms to protect itself against the complement system (or complement cascade), whose components are found with human serum.[41] There are three different pathways that activate this system however, they all result in the activation of complement protein 3 (C3).[86] A cleaved portion of this protein, C3b, is deposited on pathogenic surfaces and results in opsonization as well as the downstream activation of the membrane attack complex.[86] N. gonorrhoeae has several mechanisms to avoid this action.[15] As a whole, these mechanisms are referred to as serum resistance.[15]
History
Name origin
Neisseria gonorrhoeae is named for Albert Neisser, who isolated it as the causative agent of the disease gonorrhea in 1878.[15][3] Galen (130 AD) coined the term "gonorrhea" from the Greek gonos which means "seed" and rhoe which means "flow".[87][9] Thus, gonorrhea means "flow of seed", a description referring to the white penile discharge, assumed to be semen, seen in male infection.[15]
Discovery
In 1878, Albert Neisser isolated and visualized N. gonorrhoeae diplococci in samples of pus from 35 men and women with the classic symptoms of genitourinary infection with gonorrhea – two of whom also had infections of the eyes.[9] In 1882, Leistikow and Loeffler were able to grow the organism in culture.[15] Then in 1883, Max Bockhart proved conclusively that the bacterium isolated by Albert Neisser was the causative agent of the disease known as gonorrhea by inoculating the penis of a healthy man with the bacteria.[9] The man developed the classic symptoms of gonorrhea days after, satisfying the last of Koch's postulates. Until this point, researchers debated whether syphilis and gonorrhea were manifestations of the same disease or two distinct entities.[88][9] One such 18th-century researcher, John Hunter, tried to settle the debate in 1767[9] by inoculating a man with pus taken from a patient with gonorrhea. He erroneously concluded that syphilis and gonorrhea were indeed the same disease when the man developed the copper-colored rash that is classic for syphilis.[86][88] Although many sources repeat that Hunter inoculated himself,[86][15] others have argued that it was another man.[89] After Hunter's experiment other scientists sought to disprove his conclusions by inoculating other male physicians, medical students,[15] and incarcerated men with gonorrheal pus, who all developed the burning and discharge of gonorrhea. One researcher, Ricord, took the initiative to perform 667 inoculations of gonorrheal pus on patients of a mental hospital, with zero cases of syphilis.[9][15] Notably, the advent of penicillin in the 1940s made effective treatments for gonorrhea available.[90]
See also
References
- ^ Euzéby JP, Parte AC. "Genus Neisseria". List of Prokaryotic Names with Standing in Nomenclature (LPSN). Retrieved 7 July 2017.
- ^ Neisser A (1879). "Ueber eine der Gonorrhoe eigentümliche Micrococusform" [About a micrococus form peculiar to gonorrhea]. Centralblatt für die medizinischen Wissenschaften (in German). 17 (28): 497–500.
- ^ a b c O'Donnell JA, Gelone SP (2009). "Bacterial Cause of PID: Gonorrhoeae". Pelvic Inflammatory Disease. Infobase Publishing. ISBN 978-1-4381-0159-0.
- ^ Inaba S, Aizawa Y, Kataoka S, Saitoh A (December 2023). "Purulent nasal discharge due to gonococcal nasopharyngitis in a neonate". Journal of Infection and Chemotherapy. 29 (12): 1164–1166. doi:10.1016/j.jiac.2023.08.005. PMID 37558089.
- ^ Mahapure K, Singh A (August 2023). "A Review of Recent Advances in Our Understanding of Neisseria gonorrhoeae". Cureus. 15 (8): e43464. doi:10.7759/cureus.43464. PMC 10498933. PMID 37711920.
- ^ a b c d e f g h i j k Ryan KJ, Ray CG, eds. (2004). Sherris Medical Microbiology (4th ed.). McGraw Hill. ISBN 978-0-8385-8529-0.
- ^ a b c d "Detailed STD Facts - Gonorrhea". www.cdc.gov. 26 September 2017. Retrieved 7 December 2017.
- ^ a b c d "2015 Sexually Transmitted Diseases Treatment Guidelines". CDC. Centers for Disease Control and Prevention, U.S. Department of Health & Human Services. Archived from the original on 22 December 2015.
- ^ a b c d e f g h i j k l m n o p q Hill SA, Masters TL, Wachter J (September 2016). "Gonorrhea - an evolving disease of the new millennium". Microbial Cell. 3 (9): 371–389. doi:10.15698/mic2016.09.524. PMC 5354566. PMID 28357376.
- ^ "Final Recommendation Statement: Chlamydia and Gonorrhea: Screening". U.S. Preventive Services Task Force. Retrieved 7 December 2017.
- ^ a b c d e f Levinson W (2014). Review of medical microbiology and immunology. McGraw-Hill Education. ISBN 978-0-07-181811-7. OCLC 871305336.
- ^ a b c d e Ng LK, Martin IE (January 2005). "The laboratory diagnosis of Neisseria gonorrhoeae". The Canadian Journal of Infectious Diseases & Medical Microbiology. 16 (1): 15–25. doi:10.1155/2005/323082. PMC 2095009. PMID 18159523.
- ^ "Gonococcal Infections - 2015 STD Treatment Guidelines". 4 January 2018.
- ^ MacKenzie CR, Henrich B, eds. (2012). Diagnosis of sexually transmitted diseases: methods and protocols. Humana Press. ISBN 978-1-61779-936-5. OCLC 781681739.
- ^ a b c d e f g h i j k Quillin SJ, Seifert HS (April 2018). "Neisseria gonorrhoeae host adaptation and pathogenesis". Nature Reviews. Microbiology. 16 (4): 226–240. doi:10.1038/nrmicro.2017.169. PMC 6329377. PMID 29430011.
- ^ Costa-Lourenço AP, Barros Dos Santos KT, Moreira BM, Fracalanzza SE, Bonelli RR (1 October 2017). "Antimicrobial resistance in Neisseria gonorrhoeae: history, molecular mechanisms and epidemiological aspects of an emerging global threat". Brazilian Journal of Microbiology. 48 (4): 617–628. doi:10.1016/j.bjm.2017.06.001. PMC 5628311. PMID 28754299.
- ^ Sell J, Nasir M, Courchesne C (May 2021). "Urethritis: Rapid Evidence Review". American Family Physician. 103 (9): 553–558. PMID 33929174.
- ^ Van Putten J, Tønjum T (2010). "Neisseria". Infectious Diseases. pp. 1676–1689. doi:10.1016/b978-0-323-04579-7.00168-4. ISBN 978-0-323-04579-7.
- ^ a b c d e f g h i j k l m n o p q r s t Green LR, Cole J, Parga EF, Shaw JG (2022). Neisseria gonorrhoeae physiology and pathogenesis. Advances in Microbial Physiology. Vol. 80. pp. 35–83. doi:10.1016/bs.ampbs.2022.01.002. ISBN 978-0-323-98869-8. PMID 35489793.
- ^ Silva MT (2012). "Classical labeling of bacterial pathogens according to their lifestyle in the host: inconsistencies and alternatives". Frontiers in Microbiology. 3: 71. doi:10.3389/fmicb.2012.00071. PMC 3289908. PMID 22393329.
- ^ a b Yeshanew AG, Geremew RA (17 July 2018). "Neisseria Gonorrhoae and their antimicrobial susceptibility patterns among symptomatic patients from Gondar town, north West Ethiopia". Antimicrobial Resistance and Infection Control. 7 (1) 85. doi:10.1186/s13756-018-0376-3. PMC 6050735. PMID 30026943.
- ^ Tønjum T, Van Putten J (2017). "Neisseria". Infectious Diseases. pp. 1553–1564.e1. doi:10.1016/B978-0-7020-6285-8.00179-9. ISBN 978-0-7020-6285-8.
Endospores and exotoxins are not found and flagella are absent. Some Neisseria spp., including N. gonorrhoeae and N. meningitidis, may show surface-bound twitching motility due to pilus retraction.
- ^ Gray-Owen SD, Dehio C, Rudel T, Naumann M, Meyer TF (2001). "Neisseria". Principles of Bacterial Pathogenesis. pp. 559–618. doi:10.1016/b978-012304220-0/50013-3. ISBN 978-0-12-304220-0.
- ^ Eriksson J, Eriksson OS, Maudsdotter L, Palm O, Engman J, Sarkissian T, et al. (April 2015). "Characterization of motility and piliation in pathogenic Neisseria". BMC Microbiology. 15 (1) 92. doi:10.1186/s12866-015-0424-6. PMC 4449605. PMID 25925502.
- ^ Ladhani SN, Lucidarme J, Parikh SR, Campbell H, Borrow R, Ramsay ME (June 2020). "Meningococcal disease and sexual transmission: urogenital and anorectal infections and invasive disease due to Neisseria meningitidis". Lancet. 395 (10240): 1865–1877. doi:10.1016/S0140-6736(20)30913-2. PMID 32534649. S2CID 219701418.
- ^ Groisman EA, ed. (2001). Principles of bacterial pathogenesis. San Diego, Calif: Academic Press. ISBN 978-0-12-304220-0.
- ^ a b c d e Morse SA, Cacciapuoti AF, Lysko PG (1 January 1980). "Physiology of Neisseria gonorrhoeae". In Rose AH, Morris JG (eds.). Advances in Microbial Physiology Volume 20. Vol. 20. Academic Press. pp. 251–320. doi:10.1016/s0065-2911(08)60209-x. ISBN 978-0-12-027720-9. PMID 43667.
- ^ a b c Morse SA, Stein S, Hines J (November 1974). "Glucose metabolism in Neisseria gonorrhoeae". Journal of Bacteriology. 120 (2): 702–714. doi:10.1128/jb.120.2.702-714.1974. PMC 245830. PMID 4156358.
- ^ a b c Hebeler BH, Morse SA (October 1976). "Physiology and metabolism of pathogenic neisseria: tricarboxylic acid cycle activity in Neisseria gonorrhoeae". Journal of Bacteriology. 128 (1): 192–201. doi:10.1128/jb.128.1.192-201.1976. PMC 232843. PMID 824268.
- ^ Ingram-Smith C, Martin SR, Smith KS (June 2006). "Acetate kinase: not just a bacterial enzyme". Trends in Microbiology. 14 (6): 249–253. doi:10.1016/j.tim.2006.04.001. PMID 16678422.
- ^ Leighton MP, Kelly DJ, Williamson MP, Shaw JG (June 2001). "An NMR and enzyme study of the carbon metabolism of Neisseria meningitidis". Microbiology. 147 (Pt 6): 1473–1482. doi:10.1099/00221287-147-6-1473. PMID 11390678.
- ^ a b Atack JM, Ibranovic I, Ong CL, Djoko KY, Chen NH, Vanden Hoven R, et al. (October 2014). "A role for lactate dehydrogenases in the survival of Neisseria gonorrhoeae in human polymorphonuclear leukocytes and cervical epithelial cells". The Journal of Infectious Diseases. 210 (8): 1311–1318. doi:10.1093/infdis/jiu230. PMC 4215069. PMID 24737798.
- ^ a b c Li Y, Hopper A, Overton T, Squire DJ, Cole J, Tovell N (May 2010). "Organization of the electron transfer chain to oxygen in the obligate human pathogen Neisseria gonorrhoeae: roles for cytochromes c4 and c5, but not cytochrome c2, in oxygen reduction". Journal of Bacteriology. 192 (9): 2395–2406. doi:10.1128/JB.00002-10. PMC 2863483. PMID 20154126.
- ^ a b c d e f Aspholm M, Aas FE, Harrison OB, Quinn D, Vik A, Viburiene R, et al. (August 2010). "Structural alterations in a component of cytochrome c oxidase and molecular evolution of pathogenic Neisseria in humans". PLOS Pathogens. 6 (8): e1001055. doi:10.1371/journal.ppat.1001055. PMC 2924362. PMID 20808844.
- ^ Hopper A, Tovell N, Cole J (December 2009). "A physiologically significant role in nitrite reduction of the CcoP subunit of the cytochrome oxidase cbb 3 from Neisseria gonorrhoeae". FEMS Microbiology Letters. 301 (2): 232–240. doi:10.1111/j.1574-6968.2009.01824.x. PMID 19889029.
- ^ a b Anraku Y (June 1988). "Bacterial electron transport chains". Annual Review of Biochemistry. 57 (1): 101–132. doi:10.1146/annurev.bi.57.070188.000533. PMID 3052268.
- ^ a b Trumpower BL (June 1990). "Cytochrome bc1 complexes of microorganisms". Microbiological Reviews. 54 (2): 101–129. doi:10.1128/mr.54.2.101-129.1990. PMC 372766. PMID 2163487.
- ^ a b "UniProt". www.uniprot.org. Retrieved 18 November 2024.
- ^ a b Capaldi RA, Aggeler R (March 2002). "Mechanism of the F(1)F(0)-type ATP synthase, a biological rotary motor". Trends in Biochemical Sciences. 27 (3): 154–160. doi:10.1016/s0968-0004(01)02051-5. PMID 11893513.
- ^ a b c Stoudenmire JL, Greenawalt AN, Cornelissen CN (15 September 2022). "Stealthy microbes: How Neisseria gonorrhoeae hijacks bulwarked iron during infection". Frontiers in Cellular and Infection Microbiology. 12: 1017348. doi:10.3389/fcimb.2022.1017348. PMC 9519893. PMID 36189345.
- ^ a b c d e Edwards JL, Apicella MA (October 2004). "The molecular mechanisms used by Neisseria gonorrhoeae to initiate infection differ between men and women". Clinical Microbiology Reviews. 17 (4): 965–81, table of contents. doi:10.1128/CMR.17.4.965-981.2004. PMC 523569. PMID 15489357.
- ^ "STI Awareness: Gonorrhea". Planned Parenthood Advocates of Arizona. 11 April 2011. Archived from the original on 3 November 2012. Retrieved 31 August 2011.
- ^ Sadarangani M, Pollard AJ, Gray-Owen SD (May 2011). "Opa proteins and CEACAMs: pathways of immune engagement for pathogenic Neisseria". FEMS Microbiology Reviews. 35 (3): 498–514. doi:10.1111/j.1574-6976.2010.00260.x. PMID 21204865.
- ^ a b Hu LI, Yin S, Ozer EA, Sewell L, Rehman S, Garnett JA, et al. (October 2020). Justice S (ed.). "Discovery of a New Neisseria gonorrhoeae Type IV Pilus Assembly Factor, TfpC". mBio. 11 (5). doi:10.1128/mBio.02528-20. PMC 7593972. PMID 33109763.
- ^ a b Merz AJ, So M, Sheetz MP (September 2000). "Pilus retraction powers bacterial twitching motility". Nature. 407 (6800): 98–102. Bibcode:2000Natur.407...98M. doi:10.1038/35024105. PMID 10993081.
- ^ Stern A, Brown M, Nickel P, Meyer TF (October 1986). "Opacity genes in Neisseria gonorrhoeae: control of phase and antigenic variation". Cell. 47 (1): 61–71. doi:10.1016/0092-8674(86)90366-1. PMID 3093085. S2CID 21366517.
- ^ Cahoon LA, Seifert HS (September 2011). "Focusing homologous recombination: pilin antigenic variation in the pathogenic Neisseria". Molecular Microbiology. 81 (5): 1136–1143. doi:10.1111/j.1365-2958.2011.07773.x. PMC 3181079. PMID 21812841.
- ^ Obergfell KP, Seifert HS (February 2015). "Mobile DNA in the pathogenic Neisseria". Microbiology Spectrum. 3 (3). doi:10.1128/microbiolspec.MDNA3-0015-2014. PMC 4389775. PMID 25866700.
- ^ Aas FE, Wolfgang M, Frye S, Dunham S, Løvold C, Koomey M (November 2002). "Competence for natural transformation in Neisseria gonorrhoeae: components of DNA binding and uptake linked to type IV pilus expression". Molecular Microbiology. 46 (3): 749–760. doi:10.1046/j.1365-2958.2002.03193.x. PMID 12410832. S2CID 21854666.
- ^ Simons MP, Nauseef WM, Apicella MA (April 2005). "Interactions of Neisseria gonorrhoeae with adherent polymorphonuclear leukocytes". Infection and Immunity. 73 (4): 1971–1977. doi:10.1128/iai.73.4.1971-1977.2005. PMC 1087443. PMID 15784537.
- ^ Escobar A, Rodas PI, Acuña-Castillo C (2018). "Macrophage-Neisseria gonorrhoeae Interactions: A Better Understanding of Pathogen Mechanisms of Immunomodulation". Frontiers in Immunology. 9: 3044. doi:10.3389/fimmu.2018.03044. PMC 6309159. PMID 30627130.
- ^ Stohl EA, Seifert HS (November 2006). "Neisseria gonorrhoeae DNA recombination and repair enzymes protect against oxidative damage caused by hydrogen peroxide". Journal of Bacteriology. 188 (21): 7645–7651. doi:10.1128/JB.00801-06. PMC 1636252. PMID 16936020.
- ^ Michod RE, Bernstein H, Nedelcu AM (May 2008). "Adaptive value of sex in microbial pathogens". Infection, Genetics and Evolution. 8 (3): 267–285. Bibcode:2008InfGE...8..267M. doi:10.1016/j.meegid.2008.01.002. PMID 18295550.
- ^ Blokesch M (November 2016). "Natural competence for transformation". Current Biology. 26 (21): R1126 – R1130. Bibcode:2016CBio...26R1126B. doi:10.1016/j.cub.2016.08.058. PMID 27825443.
- ^ "Neisseria gonorrhoeae genome statistics". Broad Institute. Retrieved 8 April 2017.
- ^ Chung GT, Yoo JS, Oh HB, Lee YS, Cha SH, Kim SJ, et al. (September 2008). "Complete genome sequence of Neisseria gonorrhoeae NCCP11945". Journal of Bacteriology. 190 (17): 6035–6036. doi:10.1128/JB.00566-08. PMC 2519540. PMID 18586945.
- ^ Burmeister AR (July 2015). "Horizontal Gene Transfer". Evolution, Medicine, and Public Health. 2015 (1): 193–194. doi:10.1093/emph/eov018. PMC 4536854. PMID 26224621.
- ^ Unemo M, Shafer WM (August 2011). "Antibiotic resistance in Neisseria gonorrhoeae: origin, evolution, and lessons learned for the future". Annals of the New York Academy of Sciences. 1230 (1): E19 – E28. Bibcode:2011NYASA1230E..19U. doi:10.1111/j.1749-6632.2011.06215.x. PMC 4510988. PMID 22239555.
- ^ Spencer-Smith R, Roberts S, Gurung N, Snyder LA (August 2016). "DNA uptake sequences in Neisseria gonorrhoeae as intrinsic transcriptional terminators and markers of horizontal gene transfer". Microbial Genomics. 2 (8): e000069. doi:10.1099/mgen.0.000069. PMC 5320588. PMID 28348864.
- ^ Manoharan-Basil SS, González N, Laumen JG, Kenyon C (17 March 2022). "Horizontal Gene Transfer of Fluoroquinolone Resistance-Conferring Genes From Commensal Neisseria to Neisseria gonorrhoeae: A Global Phylogenetic Analysis of 20,047 Isolates". Frontiers in Microbiology. 13: 793612. doi:10.3389/fmicb.2022.793612. PMC 8973304. PMID 35369513.
- ^ Hamilton HL, Dillard JP (January 2006). "Natural transformation of Neisseria gonorrhoeae: from DNA donation to homologous recombination". Molecular Microbiology. 59 (2): 376–385. doi:10.1111/j.1365-2958.2005.04964.x. PMID 16390436.
- ^ a b c Cehovin A, Lewis SB (August 2017). "Mobile genetic elements in Neisseria gonorrhoeae: movement for change". Pathogens and Disease. 75 (6). doi:10.1093/femspd/ftx071. PMID 28645177.
- ^ Kravtsov D, Gryadunov D, Shaskolskiy B (June 2023). "Gonococcal Genetic Island in the Global Neisseria gonorrhoeae Population: A Model of Genetic Diversity and Association with Resistance to Antimicrobials". Microorganisms. 11 (6): 1547. doi:10.3390/microorganisms11061547. PMC 10301925. PMID 37375049.
- ^ Zweig M, Schork S, Koerdt A, Siewering K, Sternberg C, Thormann K, et al. (April 2014). "Secreted single-stranded DNA is involved in the initial phase of biofilm formation by Neisseria gonorrhoeae" (PDF). Environmental Microbiology. 16 (4): 1040–1052. Bibcode:2014EnvMi..16.1040Z. doi:10.1111/1462-2920.12291. PMID 24119133.
- ^ Anderson MT, Seifert HS (May 2011). "Neisseria gonorrhoeae and humans perform an evolutionary LINE dance". Mobile Genetic Elements. 1 (1): 85–87. doi:10.4161/mge.1.1.15868. PMC 3190277. PMID 22016852.
- ^ Anderson MT, Seifert HS (2011). "Opportunity and means: horizontal gene transfer from the human host to a bacterial pathogen". mBio. 2 (1): e00005 – e00011. doi:10.1128/mBio.00005-11. PMC 3042738. PMID 21325040.
- ^ Detels R, Green AM, Klausner JD, Katzenstein D, Gaydos C, Handsfield H, et al. (June 2011). "The incidence and correlates of symptomatic and asymptomatic Chlamydia trachomatis and Neisseria gonorrhoeae infections in selected populations in five countries". Sexually Transmitted Diseases. 38 (6): 503–509. doi:10.1097/OLQ.0b013e318206c288. PMC 3408314. PMID 22256336.
- ^ a b c d e f g h i j Ryan KJ, Ray CG, eds. (2004). Sherris Medical Microbiology (4th ed.). McGraw Hill. ISBN 978-0-8385-8529-0.
- ^ a b c "Gonococcal Infections - 2015 STD Treatment Guidelines". www.cdc.gov. Retrieved 7 December 2017.
- ^ "Gonorrhea (the clap) Symptoms". std-gov.org. 2 April 2015.
- ^ Goodyear-Smith F (November 2007). "What is the evidence for non-sexual transmission of gonorrhoea in children after the neonatal period? A systematic review". Journal of Forensic and Legal Medicine. 14 (8): 489–502. doi:10.1016/j.jflm.2007.04.001. PMID 17961874.
- ^ Anderson MT, Dewenter L, Maier B, Seifert HS (March 2014). "Seminal plasma initiates a Neisseria gonorrhoeae transmission state". mBio. 5 (2): e01004 – e01013. doi:10.1128/mBio.01004-13. PMC 3958800. PMID 24595372.
- ^ a b Meyer T, Buder S (January 2020). "The Laboratory Diagnosis of Neisseria gonorrhoeae: Current Testing and Future Demands". Pathogens. 9 (2): 91. doi:10.3390/pathogens9020091. PMC 7169389. PMID 32024032.
- ^ Cosentino LA, Campbell T, Jett A, Macio I, Zamborsky T, Cranston RD, et al. (June 2012). "Use of nucleic acid amplification testing for diagnosis of anorectal sexually transmitted infections". Journal of Clinical Microbiology. 50 (6): 2005–2008. doi:10.1128/JCM.00185-12. PMC 3372150. PMID 22493338.
- ^ a b c d "Gonococcal Infections Among Adolescents and Adults - STI Treatment Guidelines". www.cdc.gov. 5 December 2022. Retrieved 19 November 2024.
- ^ a b c Williams E, Seib KL, Fairley CK, Pollock GL, Hocking JS, McCarthy JS, et al. (March 2024). Forrest GN (ed.). "Neisseria gonorrhoeae vaccines: a contemporary overview". Clinical Microbiology Reviews. 37 (1): e0009423. doi:10.1128/cmr.00094-23. PMC 10938898. PMID 38226640.
- ^ Clinical trial number NCT05630859 for "Safety and Efficacy of GSK Neisseria Gonorrhoeae GMMA (NgG) Investigational Vaccine When Administered to Healthy Adults 18 to 50 Years of Age." at ClinicalTrials.gov
- ^ "GSK receives US FDA Fast Track designation for investigational vaccine against gonorrhoea" (Press release). GSK. 27 June 2023. Archived from the original on 24 July 2025. Retrieved 24 July 2025.
- ^ Rogers A, Gallagher J (21 May 2025). "World-first gonorrhoea vaccine launched by NHS England as infections soar". BBC News. Archived from the original on 24 July 2025. Retrieved 24 July 2025.
- ^ "Gonorrhoea vaccine". Vaccine Knowledge Project. Oxford Vaccine Group, University of Oxford. 20 June 2025. Archived from the original on 24 July 2025. Retrieved 24 July 2025.
- ^ CDC (16 May 2024). "Drug-Resistant Gonorrhea". Gonorrhea. Retrieved 20 November 2024.
- ^ St Cyr S, Barbee L, Workowski KA, Bachmann LH, Pham C, Schlanger K, et al. (December 2020). "Update to CDC's Treatment Guidelines for Gonococcal Infection, 2020". MMWR. Morbidity and Mortality Weekly Report. 69 (50): 1911–1916. doi:10.15585/mmwr.mm6950a6. PMC 7745960. PMID 33332296.
- ^ "UK doctors advised gonorrhoea has turned drug resistant". BBC News. 10 October 2011.
- ^ a b "STI Awareness: Antibiotic-Resistant Gonorrhea". Planned Parenthood Advocates of Arizona. 6 March 2012. Archived from the original on 5 November 2012. Retrieved 6 March 2012.
- ^ Tuddenham S, Hamill MM, Ghanem KG (January 2022). "Diagnosis and Treatment of Sexually Transmitted Infections: A Review". JAMA. 327 (2): 161–172. doi:10.1001/jama.2021.23487. PMID 35015033.
- ^ a b c d Charles A Janeway J, Travers P, Walport M, Shlomchik MJ (2001). "The complement system and innate immunity". Immunobiology: The Immune System in Health and Disease. 5th edition. Garland Science.
- ^ "gonorrhea | Origin and meaning of gonorrhea by Online Etymology Dictionary". www.etymonline.com. Retrieved 5 December 2017.
- ^ a b Singal A, Grover C (2016). Comprehensive Approach to Infections in Dermatology. JP Medical. p. 470. ISBN 978-93-5152-748-0.
- ^ Gladstein J (July 2005). "Hunter's chancre: did the surgeon give himself syphilis?". Clinical Infectious Diseases. 41 (1): 128, author reply 128-128, author reply 129. doi:10.1086/430834. PMID 15937780.
- ^ Jose PP, Vivekanandan V, Sobhanakumari K (15 October 2020). "Gonorrhea: Historical outlook". Journal of Skin and Sexually Transmitted Diseases. 2 110: 110–114. doi:10.25259/JSSTD_4_2020.
External links
- Todar K. "Pathogenic Neisseriae: Gonorrhea, Neonatal Ophthalmia and Meningococcal Meningitis". Todar's Online Textbook of Bacteriology.
- Gonorrhea at eMedicine
- "Neisseria gonorrhoeae". NCBI Taxonomy Browser. 485.
